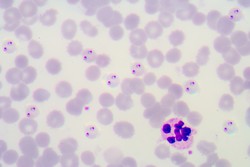

Diagnóstico rápido y fácil de la malaria
Según la Organización Mundial de la Salud, cerca de la mitad de la población mundial está en riesgo de contraer la malaria. Representa por tanto una prioridad sanitaria a nivel mundial; no en vano, se calcula que hay 212 millones de casos en todo el planeta, mientras que las muertes en 2015 fueron 430 000. Dotado con fondos de la UE, el proyecto NANOMAL(se abrirá en una nueva ventana) (Development of a handheld antimalarial drug resistance diagnostic device using nanowire technology) desarrolló una herramienta fácil de usar y asequible para analizar la infección y las mutaciones de la malaria en su ADN. Este dispositivo permitirá administrar tratamiento contra el parásito específico de la malaria y también determinar en tiempo real el riesgo de aparición de resistencia farmacológica y el efecto de los tratamientos contra la malaria. Este dispositivo de coste asequible, capaz de proporcionar una diagnosis en un tiempo de quince minutos tras el análisis de una gota de sangre de dedo, se ha integrado en tecnología de telefonía móvil. El sistema permitirá consultas remotas, la transferencia de datos a unidades centrales de procesamiento de datos para la monitorización global de la enfermedad y así aplicar tratamientos apropiados que mejoren los resultados. El dispositivo de NANOMAL extrae y amplifica el ADN de la muestra de sangre y, después, el ADN se une a sondas previamente inmovilizadas en la superficie de biosensores electrónicos. Esta prueba podrá detectar las cinco especies de parásitos responsables de la malaria en humanos, incluyendo la más peligrosa, la más común y la más nueva. Es más, la prueba también será capaz de detectar más de diez mutaciones asociadas con la resistencia farmacológica en la especie más peligrosa. Los componentes se han integrado en el dispositivo portátil y el cartucho de detección de la malaria, que es desechable, estará listo para su comercialización en 2018. El dispositivo ha pasado por un período prolongado de optimización y miniaturización utilizando muestras de ADN de parásitos y pruebas de laboratorio con muestras clínicas. El enorme potencial del dispositivo desarrollado por los socios del proyecto NANOMAL ha sido reconocido con la distinción como la innovación número uno en la eliminación de la malaria por la Red Global de Profesionales del Desarrollo del periódico The Guardian (Guardian Global Development Professionals Network). Ofrece un diagnóstico adecuado de la malaria y permite una intervención capaz de salvar vidas en regiones del mundo con recursos limitados.